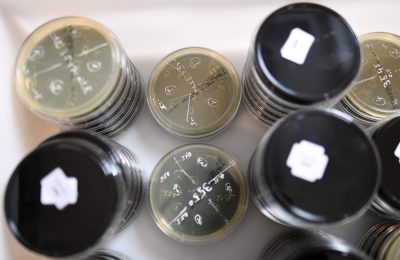

Home Posts tagged λεγεωναρίων
Tag: λεγεωναρίων, νόσος λεγεωναρίων, υπ. Υγείας
Εγκύκλιος του υπ. Υγείας για την πρόληψη της νόσου των λεγεωναρίων
Αυγ 06, 2019
Εγκύκλιο για την πρόληψη της νόσου των λεγεωναρίων ή λεγεωνέλλωση, μιας νόσου που...
ΚΕΕΛΠΝΟ: Μέτρα πρόληψης για την νόσο των λεγεωναρίων
Αυγ 03, 2018
Μέτρα πρόληψης για την «νόσο των λεγεωναρίων» προτείνει το ΚΕΕΛΠΝΟ με επίκεντρο τον έλεγχο...